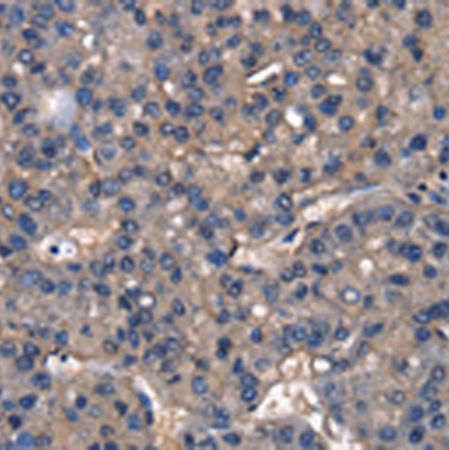
兔抗IGFBP5多克隆抗体

万千商家帮你免费找货
0 人在求购买到急需产品
- 详细信息
- 技术资料
- 抗体名:
兔抗IGFBP5多克隆抗体
- 抗体英文名:
Anti-IGFBP5 rabbit polyclonal antibody
- 应用范围:
仅供科研使用
- 宿主:
Rabbit
- 供应商:
上海酶联生物科技有限公司
- 库存:
49
- 抗原来源:
IGFBP5
- 保质期:
1年
- 适应物种:
Human, Mouse, Rat
- 标记物:
Unconjugate
- 克隆性:
多克隆
- 保存条件:
冷冻(-20℃)
- 形态:
液体
- 免疫原:
Fusion protein of human IGFBP5
- 规格:
25ul/100ul/200ul
| 规格: | 25ul | 产品价格: | ¥420.0 |
|---|---|---|---|
| 规格: | 100ul | 产品价格: | ¥1500.0 |
| 规格: | 200ul | 产品价格: | ¥2500.0 |

兔抗IGFBP5多克隆抗体
英文名称: Anti-IGFBP5 rabbit polyclonal antibody
别 名: IBP5
相关类别: 一抗
上海酶联生物专业性的技术力量使我们能够为广大用户提供强大的技术支持,深厚的人脉资源使我们在全国主要城市拥有众多合作伙伴,酶联生物配备销售队伍以及专业的技术支持,随时为客户提供技术咨询和售后服务。
实验室设计必须按照要求进行,那么要求有哪些呢?
& 精密仪器分析室
精密仪器分析室需配置许多精密仪器,所以温湿度的控制是重中之重,仪器台要选择承重性的产品,其后背板配插座,并敷设气体管路,为了及时排除废气万象排气罩也是必不可缺的,所有仪器均采用双电源供电,独立接地保护。
& 天平室
天平室也需要做温湿度的控制,所以需配置恒温恒湿系统、双层玻璃及窗帘,天平台也是不可缺少的,称重用周转台,防止干燥皿的边台,提醒:天平台要防震,需要放置在离墙大于1CM的区域。
& 洁净室
洁净室需设立洁净区、缓冲室、更衣室,室内需保持正压,空气要经过初效、中效、高效过滤器进行送风、回风等空气循环,以此确保室内的洁净度等级达标。

当您在订购我公司相关服务或产品时,为防止其他机构或个人对您实施欺诈行为,请您在签约与汇款前务必致电我司进行如下确认:
1.确认事项包括与您联系的我公司工作人员的姓名、电话
2.所订购服务或产品的名称、期限(起、止时间)
3.订购的具体金额
4.客户的汇款账户、汇款金额、汇款时间
5.客户的姓名、地址、有效联系方式、有效身份号码等重要信息
兔抗IGFBP5多克隆抗体
温馨提示:请广大客户务必确保自己的资金安全,谨防假冒信息,以免上当受骗。
同商铺产品如下

风险提示:丁香通仅作为第三方平台,为商家信息发布提供平台空间。用户咨询产品时请注意保护个人信息及财产安全,合理判断,谨慎选购商品,商家和用户对交易行为负责。对于医疗器械类产品,请先查证核实企业经营资质和医疗器械产品注册证情况。
 技术资料
技术资料兔抗IGFBP5多克隆抗体
¥420 - 2500